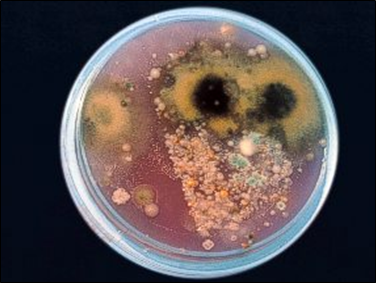
Recuentos ambientales mucho más sensibles y con muy superior diversidad de especies que los medios clásicos de recuento total.

ISO 100012 TSA-LPT NEUTRALIZING AGAR (LILAC-PURPLE) MEDIO NORMATIVO PARA RECUENTO TOTAL EN SUPERFICIES Y AIRES INTERIORES
Recuento total tras desinfecciones; para todo tipo de alimentos grasos, cosméticos, medicamentos, superficies y aire (UNE100012:2005).
COMPOSICIÓN
- Púrpura de bromocresol* 0,04 g
- Triptona 15,00 g
- Extracto de levadura 2,50 g
- Peptona de soja 5,00 g
- ClNa 5,00 g
- Dextrosa 10,00 g
- Tioglicolato sódico 1,00 g
- Tiosulfato sódico 0,60 g
- Bi sulfito sódico 2,50 g
- Lecitina 1,00 g
- Agar agar 15,00 g
(Fórmula por litro)
Ajustar a pH final: 7,8 ± 0,2
Recuentos ambientales mucho más sensibles
y con muy superior diversidad de especies que los medios clásicos de recuento total.
* En los medios preparados en placa y Envirocount, no incluimos la púrpura de bromocresol. Las placas y Envirocount con Penasa contienen respectivamente 200.000 UI y 140.000 UI por placa. Las Envirocount LPTAgar Purple con
CEX se elaboran bajo pedido para los países tropicales, dada la ingente proporción de mohos que hay en sus aires, que impide el recuento de bacterias.
PREPARACIÓN
Disolver 57,6 g de medio en 1 litro de agua bidestilada con 5 ml de Tween 80.Calentar y agitar hasta ebullición. Autoclavar a 116 ºC durante 30 minutos, o mejor a 121 ºC durante 10 minutos.Agitar hasta su solidificación para evitar la formación de grumos.
PARA USO EXCLUSIVO EN LABORATORIO.
AGITE EL BOTE ANTES DE USAR. MANTENGA
EL BOTE BIEN CERRADO EN LUGAR SECO, FRESCO Y OSCURO.
DESHIDRATADO CODIGO: DMT066
CONTROL DE CALIDAD DEL MEDIO:
Realizado en nuestro laboratorio; es prudente repetirlo en su laboratorio siempre que varíen las condiciones (más de 3 meses sin usar, tras desinfectar laboratorio, tras conservar a alta Tª, cuando adquiere aspectos extraños aunque no haya llegado la fecha de caducidad teórica de la etiqueta,…).
DESHIDRATADO: Polvo grueso, Gris
PREPARADO: Estéril, Lavanda, Turbio
CONTROL DE CRECIMIENTO CUANTITATIVO 48-72 h a 37°C aproximadamente, o bien 3-5 días a temperatura ambiente (21-28°C aproximadamente):
- Enterococcus faecalis MKTA 29212, Excelente. Colonia blanca, medio amarillo. Con respecto a PCA estandarizado*, recuento 90-220 %. Si se añadió TTC, colonias blancas y medio naranja alrededor.
- Bacillus subtillis MKTA 6633, Excelente Con respecto a PCA estandarizado*, recuento >108-276 %. Si se añadió TTC, colonias anaranjadas o doradas, medio lila alrededor que más tarde vira a naranja.
- E.coli MKTA 25922, Bueno, Colonia amarilla, medio virado a amarillo. Con respecto a PCA estandarizado*, recuento 63-127 %. Si se añadió TTC, colonias crema o rojas, medio naranja alrededor.
- Pseudomonas aeruginosa MKTA 9027, Bueno, Colonia rosada. Con respecto a PCA estandarizado*, recuento 34-122 %. Si se añadió TTC, colonias rojas o doradas, medio lila alrededor.
- Staphylococcus aureus MKTA 6538P, Excelente, Colonia crema, medio virado a amarillo. Con respecto a PCA estandarizado*, recuento 59-103 %. Si se añadió TTC, colonias anaranjadas, medio naranja alrededor.
- Candida albicans MKTA 10231, Excelente, colonias blancas. Con respecto a TSA estandarizado*, recuento 48-93 %. Si se añadió TTC, colonias blancas o rosadas, medio lila o naranja alrededor.
* El que cumple con recuperación superior al 92-125% con respecto a cepas cuantitativas trazables a la cepa tipo. Incertidumbres detectadas entre todos los lotes a lo largo de un año (la mayoría de la incertidumbre se debe a la cepa y a la proporción de cepas acompañantes inoculadas, no al medio).
PRESENTACIÓN: TUBOS PREPARADOS, FRASCOS/FRASCOTES PREPARADOS, MEDIO DESHIDRATADO. Placas y Envirocount sin púrpura de bromocresol. Placas y Envirocount con PENASA. Envirocount con CEX.
NOTA:
Medio con base TSA formulado para la detección de microorganismos totales en productos farmacéuticos, cosméticos, grasos y/o desinfectados.
La composición del medio permite asegurar una buena dispersión del inóculo. Emulsiona las grasas e inactiva los derivados de amonio cuaternario, (únicos conservantes que inactivan los medios clásicos con Lecitina yTween) y provoca una total inactivación de los demás conservantes que pueda llevar en su fórmula el cosmético, la superficie, el aire o la muestra…
…ya que está formulado para los inactivadores modernos, incluidos parabens e incluso Isotiazolinona, además de Compuestos fenólicos: fenoxietanol, feniletanol, anilidos…, Amonios cuaternarios, Surfactantes catiónicos, Aldehidos, Formaldehido, compuestos liberadores de formol, Compuestos oxidantes, peróxidos, halógenos (Flúor, Cloro, Bromo…), Imidazoles, Clohexidina, Biguanida, Sales metálicas (Cu, Zn, Hg), compuestos organomercuriales…
La recuperación es muy superior a la de los medios habituales (Esponera & Co, Técnicas de Laboratorio, Junio-92; estudio intercolaborativo, Tecnicas Lab., Nov.2001, media 200% respecto al PCA).
Este es el medio Normalizado para control de aire y superficies según Norma UNE 100012:2005
SIEMBRA E INTERPRETACIÓN
Repartir 0,1 ml en la superficie de una placa. Aplicar una Placa de Contacto un instante sobre la superficie problema, sin moverla, o bien introducirla en un aparato para control microbiológico del aire. Incubar a 21 43 ºC, durante 2 7 días. Contar todas las colonias. Un viraje prematuro del medio a amarillo o verdoso antes de la aparición de colonias indica, si la muestra no es muy ácida (es decir, de pH inferior a 5´4) que el recuento va a ser alto. Si el viraje a amarillo o verdoso ocurre antes de incubar, es que no se ha ajustado bien el pH o que la muestra es muy ácida.
El usuario es el único responsable de la eliminación de los microorganismos según la legislación medioambiental vigente. Autoclavar antes de desechar a la basura.
Si desea más información sobre nuestros TSA-LPT NEUTRALIZING AGAR (LILAC-PURPLE) rellene nuestro formulario de contacto http://www.medioscultivo.com/contacto . O si lo prefiere póngase en contacto con nosotros a través de nuestro correo electrónico microkit@microkit.es o por teléfono en el nº 91-897 46 16
https://www.microkit.es/fichas/LPT-TSA-NEUTRALIZING-AGAR-PURPLE.pdf


